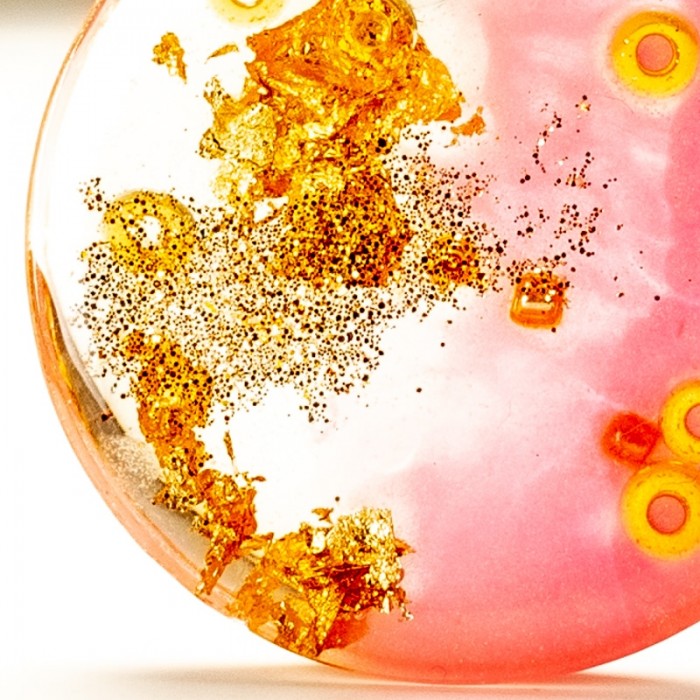
Złoto- różowy naszyjnik.

Naszyjnik – subtelna biżuteria z przesłaniem.
Biżuteria Srebrna: Sztuka w Prezencie. Naszyjnik – subtelna biżuteria z przesłaniem. Naszyjnik damski w prezencie to bardzo klasyczny pomysł....
Naszyjnik dla mamy – ręcznie malowany prezent z sercem.
Prezent sztuka w naszyjniku. Naszyjnik dla mamy – ręcznie malowany prezent z sercem. Grafikę, którą oglądasz namalowałam tuszami. Jest to jedyny i...
Naszyjnik złocony w roślinnej odsłonie.
Awangarda nowoczesna biżuteria.Naszyjnik złocony w roślinnej odsłonie. Naszyjnik damski w prezencie to bardzo klasyczny pomysł. Chcemy obdarować...
Pierścionek artystyczny ręcznie malowany z pomarańczowym oczkiem i...
Pierścionek artystyczny ze złotymi płatkami i pomarańczową grafiką zatopionymi w żywicy Pierścionek wyróżnia się tym, że namalowana grafika...
Naszyjnik z żywicy z prawdziwym fioletowym kwiatem
Naszyjnik ręcznie robiony Naszyjnik został wykonany całkowicie ręcznie. Jest oryginalny i unikalny.
Naszyjniki, Które Opowiadają Historię: Unikalna Biżuteria Ręcznie Robiona.
Naszyjniki, Które Opowiadają Historię: Unikalna Biżuteria Ręcznie Robiona. Awangarda nowoczesna biżuteria. Naszyjnik damski w prezencie to...
Długie kolczyki pozłacane turkusowe
Długie kolczyki pozłacane turkusowe Długie kolczyki pozłacane turkusowe to propozycja orginalnego i bardzo kobiecego dodatku biżuteryjnego....
Naszyjnik kula z kwiatem w żywicy biżuteria pełna spokoju
Elegancki naszyjnik. Naszyjnik kula z kwiatem w żywicy biżuteria pełna spokoju Naszyjnik damski w prezencie to bardzo klasyczny pomysł. Chcemy...












































